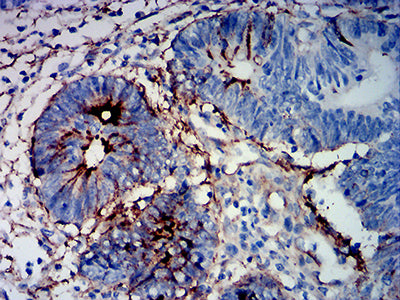

-
分类: 科研抗体货号: 31907别名: GLBA; SAP1; SAP2应用: WB,IHC反应种属: Human, Rat
-
分类: 科研抗体货号: 31889别名: MDS; KIAA1546应用: FCM反应种属: Human
-
分类: 科研抗体货号: 31906别名: GLBA; SAP1; SAP2应用: WB,IHC,IF,FCM反应种属: Human, Rat
-
分类: 科研抗体货号: 31887别名: BCL2L4应用: IHC,FCM反应种属: Human
-
分类: 科研抗体货号: 31905别名: CA125应用: IHC,FCM反应种属: Human
-
分类: 科研抗体货号: 31886别名: GUD; AWT1; WAGR; WT33; NPHS4; WIT-2应用: WB,FCM反应种属: Human, Monkey
-
分类: 科研抗体货号: 31904别名: CA125应用: IHC,FCM反应种属: Human
-
分类: 科研抗体货号: 31885别名: pax8应用: FCM反应种属: Human
-
分类: 科研抗体货号: 31903别名: GUD; AWT1; WAGR; WT33; NPHS4; WIT-2应用: WB,IHC,IF,FCM反应种属: Human, Monkey
-
分类: 科研抗体货号: 31902别名: BCL2L4应用: WB,FCM反应种属: Human

鄂公网安备42018502007531号
鄂公网安备42018502007531号

